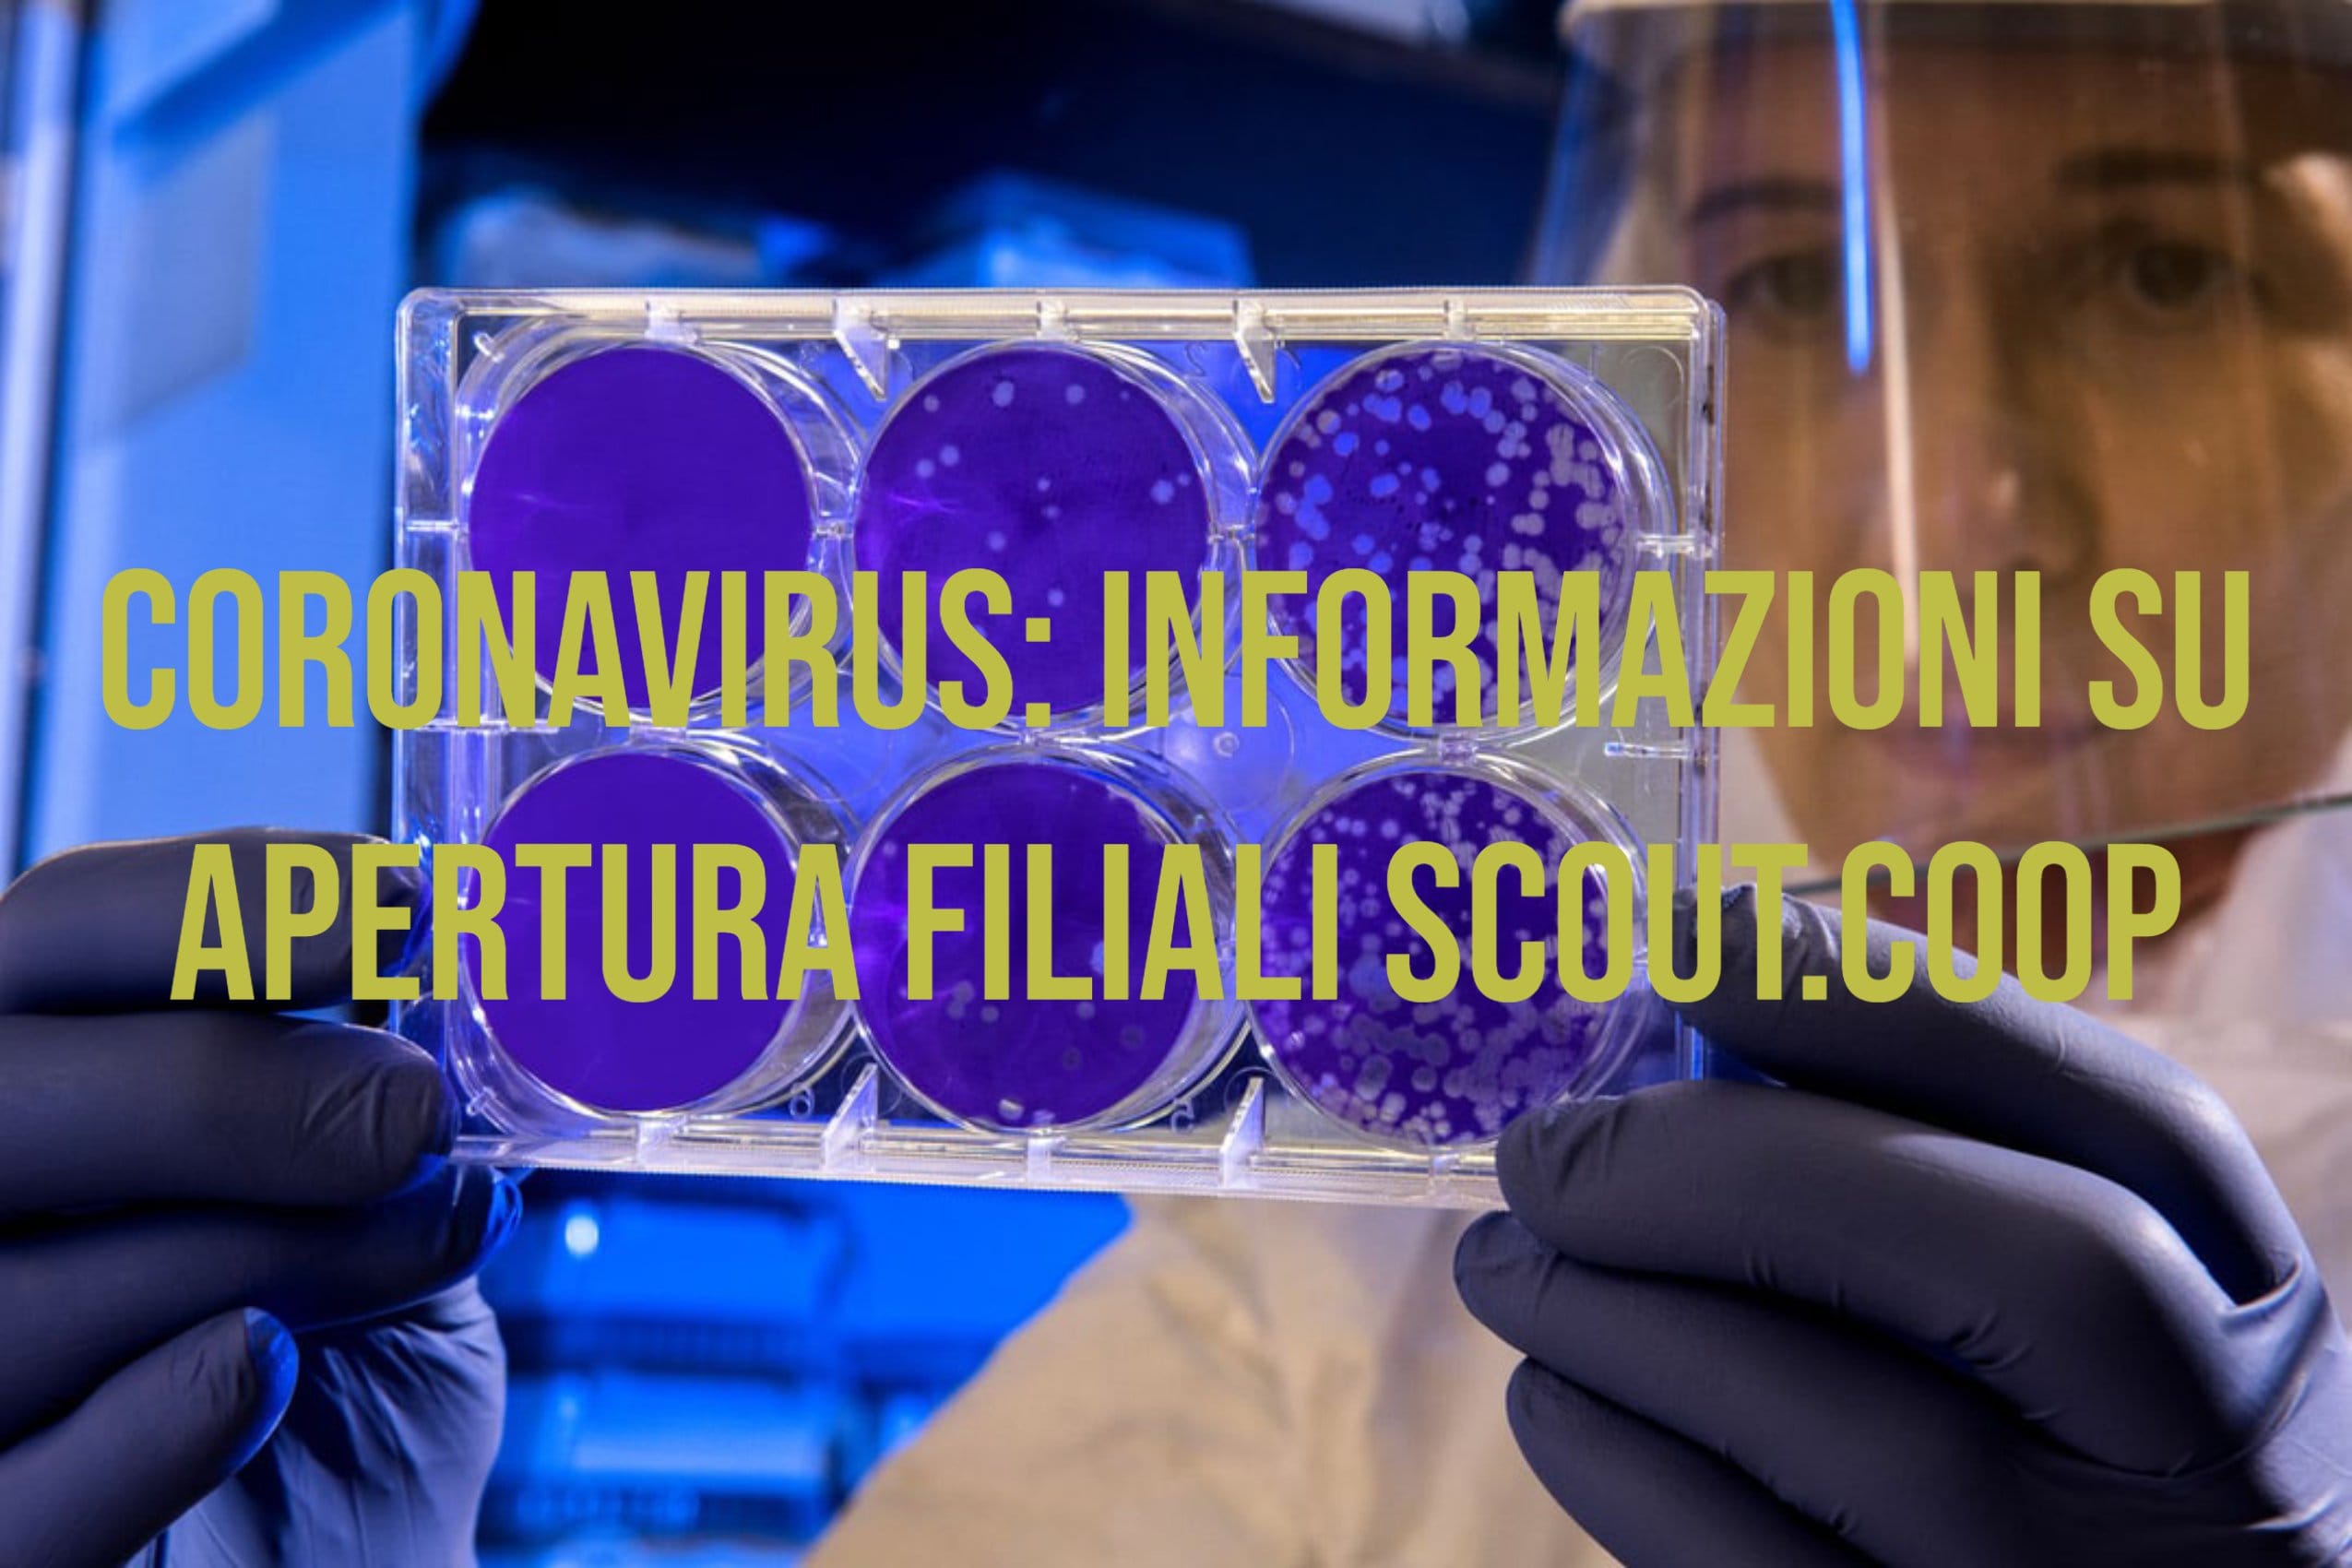

Utilizziamo tecnologie come i cookie per memorizzare e/o accedere alle informazioni del dispositivo. Lo facciamo per migliorare l'esperienza di navigazione e per mostrare annunci (non) personalizzati. Il consenso a queste tecnologie ci consentirà di elaborare dati quali il comportamento di navigazione o gli ID univoci su questo sito. Il mancato consenso o la revoca del consenso possono influire negativamente su alcune caratteristiche e funzioni.
L'archiviazione tecnica o l'accesso sono strettamente necessari al fine legittimo di consentire l'uso di un servizio specifico esplicitamente richiesto dall'abbonato o dall'utente, o al solo scopo di effettuare la trasmissione di una comunicazione su una rete di comunicazione elettronica.
L'archiviazione tecnica o l'accesso sono necessari per lo scopo legittimo di memorizzare le preferenze che non sono richieste dall'abbonato o dall'utente.
L'archiviazione tecnica o l'accesso che viene utilizzato esclusivamente per scopi statistici.
L'archiviazione tecnica o l'accesso che viene utilizzato esclusivamente per scopi statistici anonimi. Senza un mandato di comparizione, una conformità volontaria da parte del vostro Fornitore di Servizi Internet, o ulteriori registrazioni da parte di terzi, le informazioni memorizzate o recuperate per questo scopo da sole non possono di solito essere utilizzate per l'identificazione.
L'archiviazione tecnica o l'accesso sono necessari per creare profili di utenti per inviare pubblicità, o per tracciare l'utente su un sito web o su diversi siti web per scopi di marketing simili.